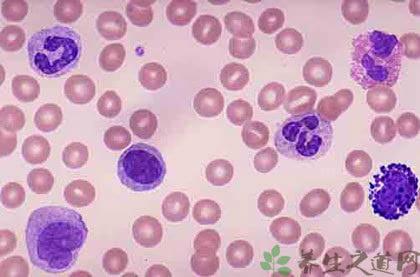
贫血会引起白细胞低吗 白细胞低 引起白细胞低的原因有哪些

说到白细胞,相信大家都曾在生物课上学到过有关于白细胞的知识,也知道白细胞具有吞噬细菌、防御疾病的作用。因此,当白细胞低的时候,则容易患病的。那是什么原因引起白细胞低的呢?白细胞低是什么好呢?今天小编就来为为大家一一解答一下。感兴趣的朋友就来看一下吧。
白细胞低的原因
白细胞低,相信很多人都有过这样的情况。那白细胞低是什么原因引起的呢?下面我们就一起来看一下吧。
1、药物
如服用解热镇痛药、磺胺类药等,此时如白细胞偏低过于明显,则应停服或换药。
2、病毒感染
如流行性感冒、病毒性感染等,此时一方面应积极进行抗病毒治疗,另方面可酌情服用增加白细胞的药物。
3、免疫系统疾病
如果患者进行放射治疗的话,则会引起白细胞遍低的,因此这个时候应该停止放疗,并且选择一些具有增加白细胞的药物服用。
4、由脾功能亢进
脾功能亢进引起的,易发生反复,严重感染,可做脾切除术。
5、感染
原虫感染如疟疾、黑热病等。立克次体感染如斑疹伤寒等。
6、生理因素或其他原因
白细胞的数值,除了疾病因素可以引起变化外,亦受生理因素及其他原因影响,餐后、剧烈运动、寒冷、疼痛、恐惧等可致白细胞升高;冬天白细胞比夏天高,下午检查比清晨高;妊娠亦可使白细胞升高。
白细胞低吃什么好
1、蘑菇木耳羹
蘑菇6~8只,黑木耳10克。
用法
将以上两种食物进行清洗干净之后放入锅中煎熬,煎好之后加冰糖进行服用即可,一天两次。
2、桑椹红枣鸡蛋汤
桑椹子20克,红枣10枚,鸡蛋2个。
用法
先将桑椹子和红枣煎水去渣,再加入鸡蛋熟后服用。
3、木耳大枣粥
黑木耳30克,大枣8枚,粳米100克。
用法
将黑木耳、大枣用温水浸泡1小时,洗净,与粳米一起煮粥服食。
爱华网



